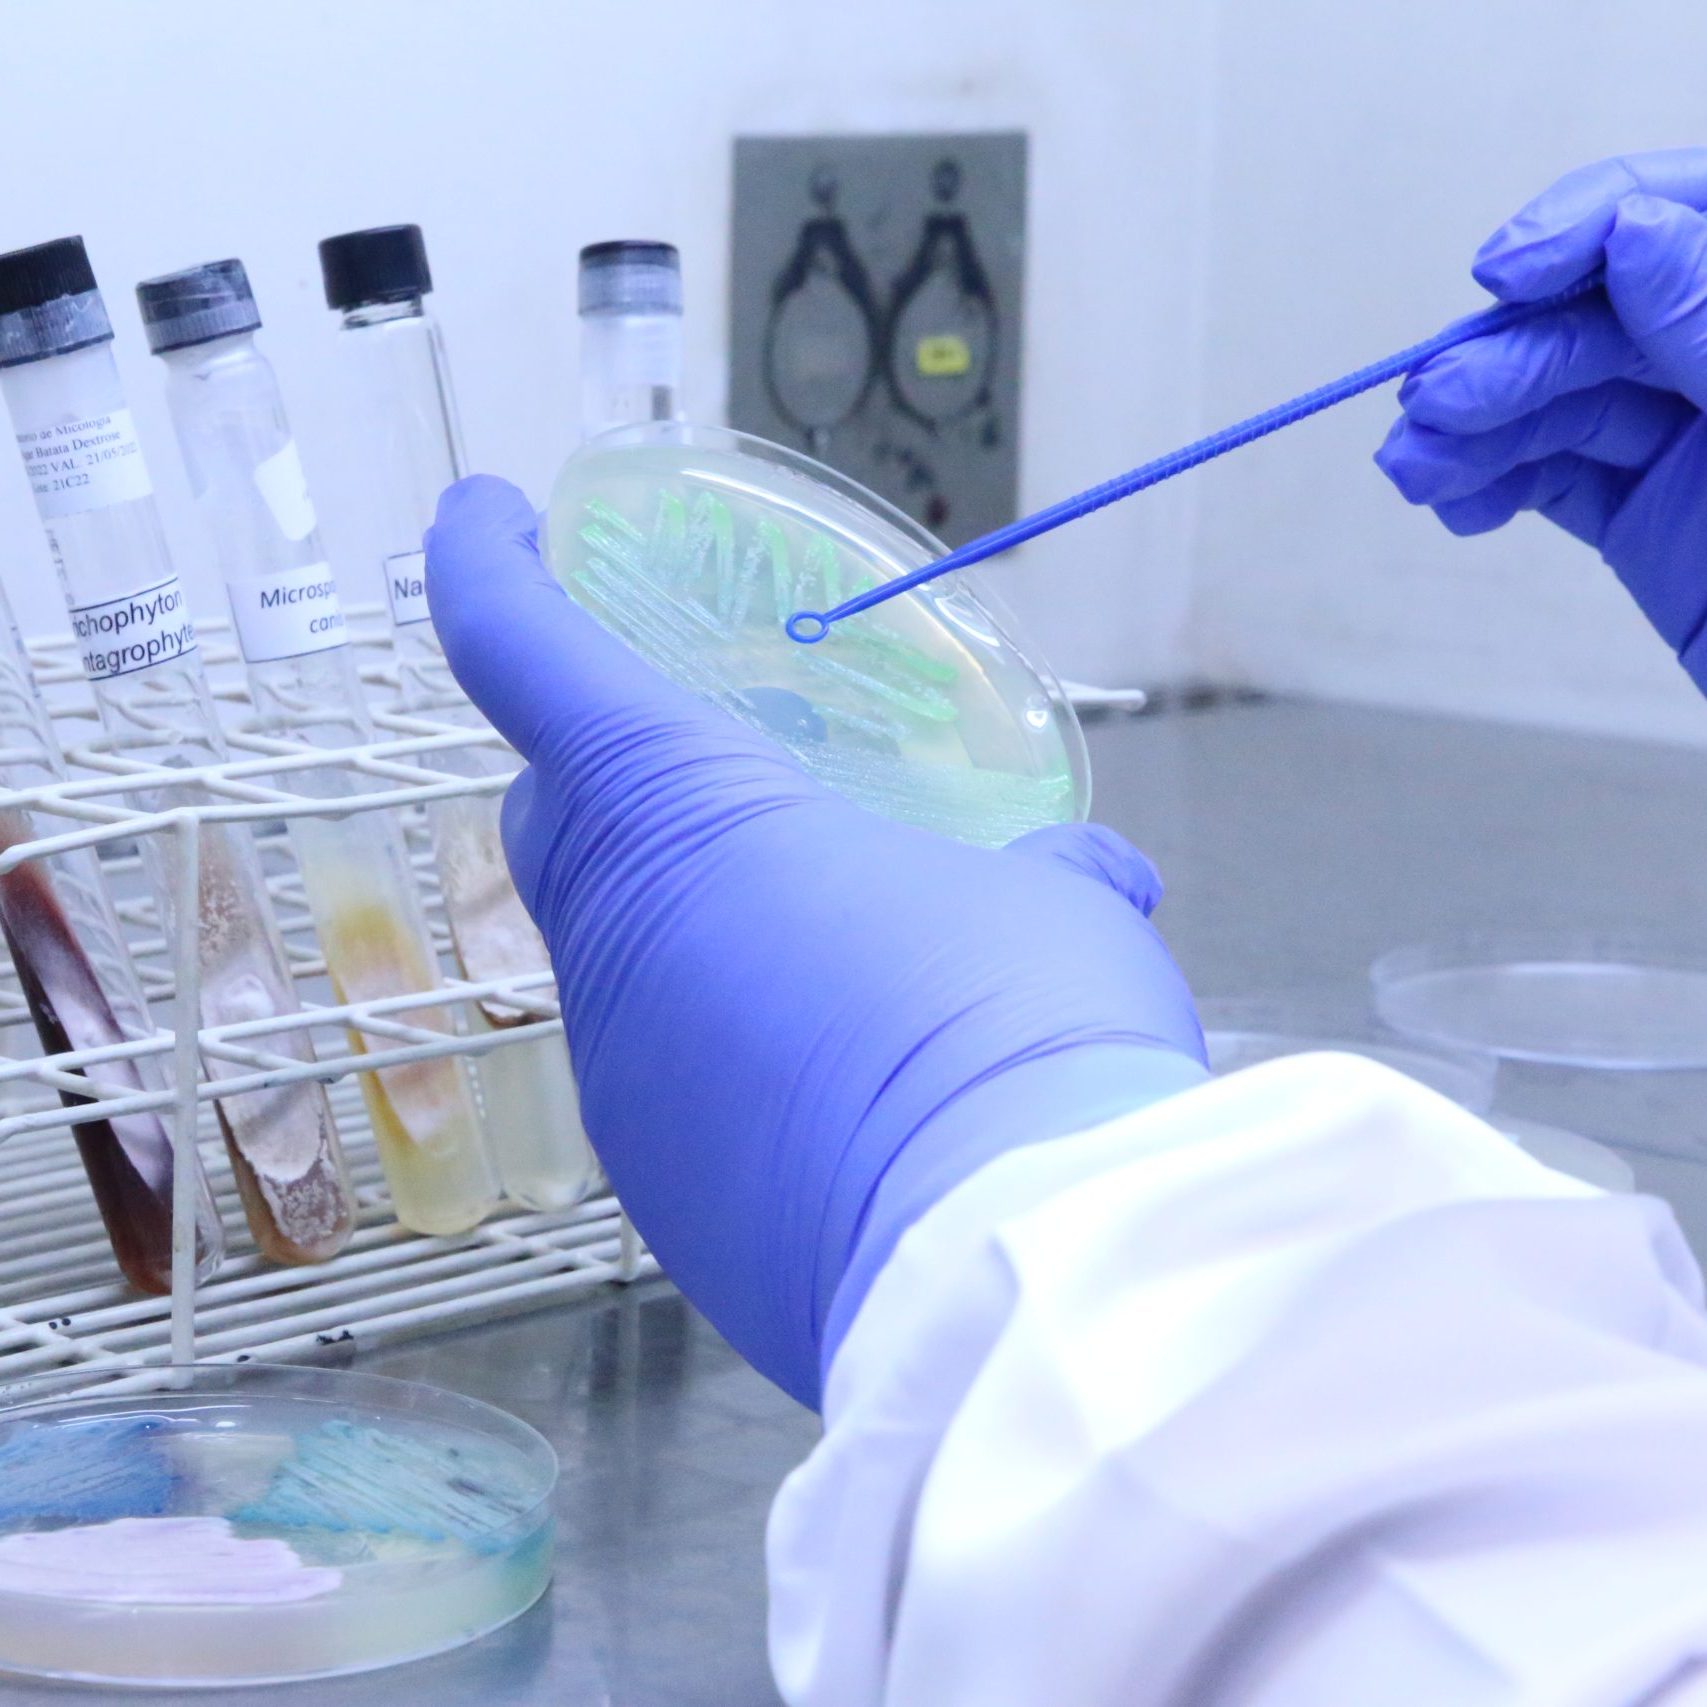

Estrutura robusta e equipe especializada garantem excelência, segurança e resultados
Desde sua fundação, em 1918, o Instituto Nacional de Infectologia Evandro Chagas (INI/Fiocruz) tem se destacado pela condução de estudos clínicos voltados para o avanço do conhecimento sobre agravos como doença de Chagas, HIV, doenças sexualmente transmissíveis, leishmanioses, tuberculose, dengue, zika, chikungunya, hepatites, micoses, zoonoses e, mais recentemente, covid-19 e mpox, entre outras.
Dotado de uma equipe multiprofissional de excelência, o Instituto dispõe de uma estrutura robusta para a realização de pesquisas, que incluem instalações para internação, leitos de terapia intensiva, ambulatórios, laboratórios e serviços de apoio. Tais recursos possibilitam que as pesquisas sejam conduzidas com qualidade, garantindo a segurança dos participantes e resultados confiáveis.
O Instituto colabora com diversos projetos em cooperação nacional e internacional, que envolvem pesquisas nas áreas específicas de atuação. Nesse contexto, a Vice-Direção de Pesquisa e Desenvolvimento Tecnológico do INI tem como objetivo coordenar e fomentar as atividades de pesquisa clínica e desenvolvimento de novas tecnologias na área da saúde, com ênfase em doenças infecciosas.